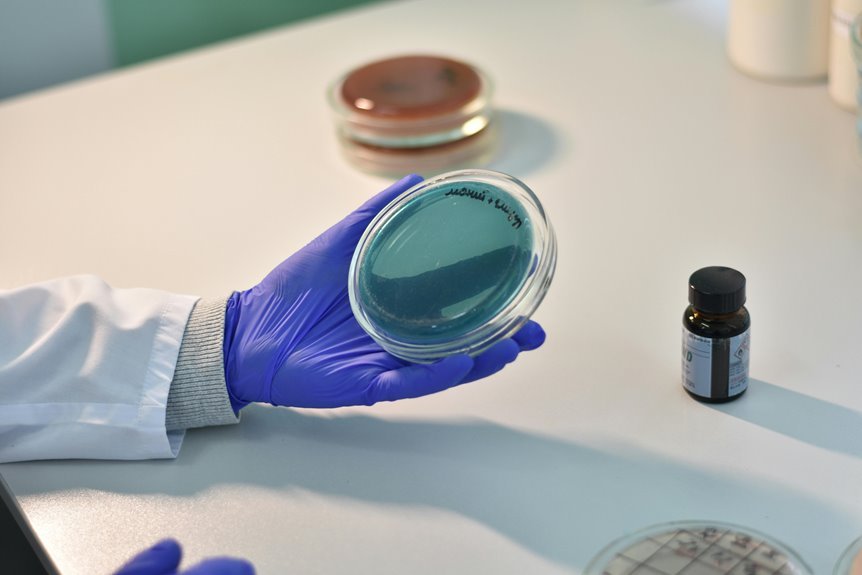
technical specifications of ds3chipdus3

You’re in for a treat with the latest updates from Redandwhitemagz.com, where creativity flourishes and fresh voices emerge. With a variety of thought-provoking articles and interviews, there’s plenty to engage your mind. The magazine’s evolving themes reflect the pulse of today’s conversations. Curious about what’s trending and what’s on the horizon? Keep exploring to uncover the stories that are shaping the narrative.
Exciting New Articles to Explore
If you’re on the lookout for fresh insights and captivating stories, you’ll love the latest articles featured on Redandwhitemagz.com.
New writers are bringing diverse article themes to life, offering you a chance to explore unique perspectives.
Dive into thought-provoking content that inspires freedom and creativity.
Each piece invites you to reflect, engage, and discover the world through fresh eyes.
Enjoy the adventure!
Trending Features and Highlights
As you dive into the latest offerings on Redandwhitemagz.com, you’ll quickly discover the trending features and highlights that are capturing readers’ attention.
From in-depth articles on hot trending topics to exclusive interviews, each feature highlight showcases unique perspectives that ignite curiosity.
Stay informed and inspired as you explore the content that resonates with your desire for freedom and knowledge.
Behind the Scenes at Redwhitemagz
Behind the scenes at Redandwhitemagz, the energy is palpable as a dedicated team collaborates to bring fresh, compelling content to life.
You’ll witness the dynamic flow of ideas during the editorial process, where each voice contributes to the final product.
This synergy fuels creativity, ensuring that every issue reflects the vibrant spirit of freedom and exploration that defines the magazine.
Upcoming Issues and What to Expect
Get ready for an exciting lineup, as the upcoming issues of Redandwhitemagz promise to deliver fresh perspectives and captivating stories.
You can look forward to issue previews showcasing innovative upcoming themes that challenge the status quo.
Each edition seeks to inspire your freedom of thought and creativity, ensuring you stay informed and engaged with the latest trends and ideas.
Don’t miss out!
Conclusion
As you dive into the latest updates at redandwhitemagz.com, you’ll discover articles that resonate with your creative spirit and curiosity. Coincidentally, you might find that the insights shared here align perfectly with your own thoughts and experiences. Stay tuned for more exciting features and behind-the-scenes glimpses that keep you connected to this vibrant community. Don’t miss out on the upcoming issues—they’ll spark ideas and inspire you in ways you never expected!